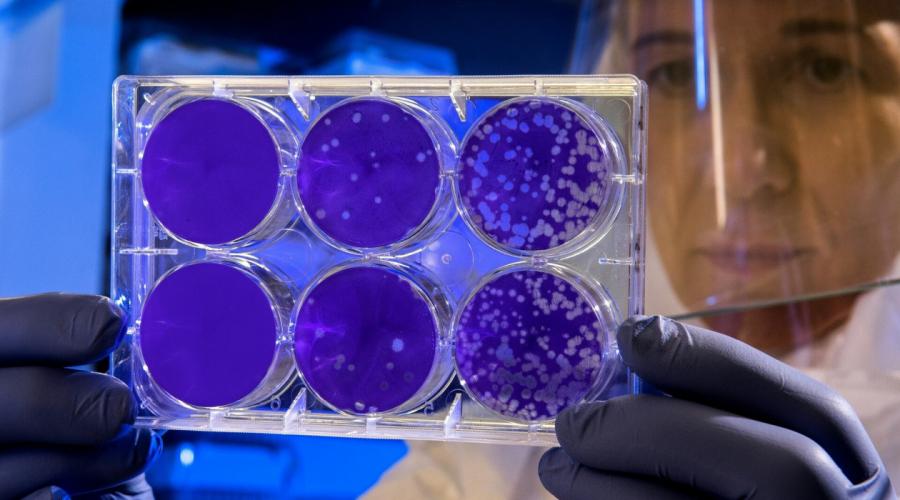

Ιός που αντέχει στο ανοσοποιητικό μπορεί να οδηγήσει σε πανδημία χειρότερη από την COVID
Ένα ιικό στέλεχος που δείχνει ανησυχητική αντοχή στο ανοσοποιητικό σύστημα του ανθρώπου μπορεί, σύμφωνα με νέα έρευνα, να αποτελέσει τον πυρήνα μιας μελλοντικής πανδημίας ακόμη πιο σοβαρής από την Covid. Επιστήμονες του Πανεπιστημίου του Κέιμπριτζ διαπιστώνουν ότι ο φυσικός θερμικός αμυντικός μηχανισμός του οργανισμού – ο πυρετός – ίσως δεν είναι αρκετός απέναντι σε ορισμένους τύπους της γρίπης των πτηνών. Η μελέτη επικεντρώθηκε σε ιούς που εντοπ